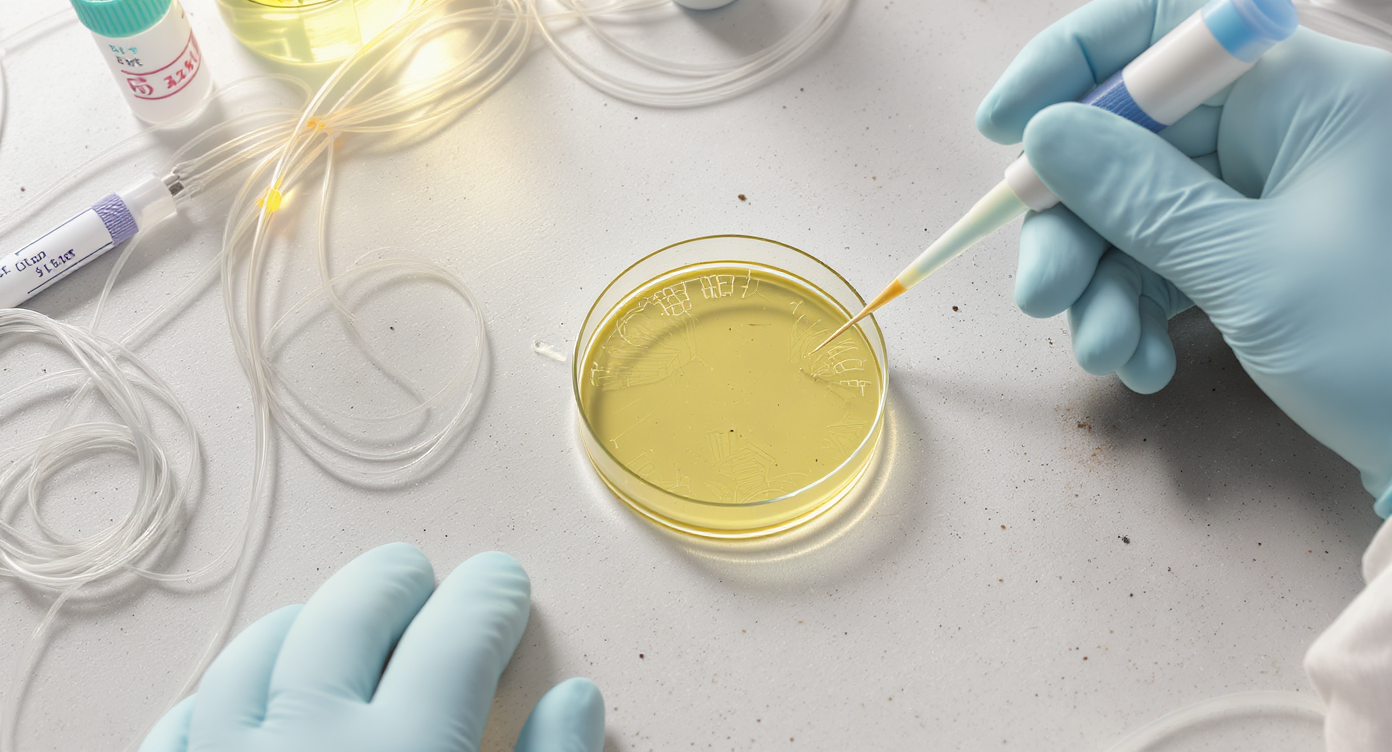

Crescimento e Fortalecimento: Tônicos e boosters com ativos tecnológicos que estimulam o bulbo e fortalecem a fibra.
Controle de Queda: Programas completos com ampolas, loções e soluções específicas.

Pós-Procedimentos: Produtos calmantes e reparadores indicados após química, barba ou técnicas invasivas.

Recuperação Intensiva: Selagens, reconstrutores moleculares e tratamentos de choque formulados sob demanda.
